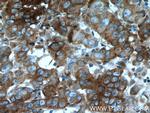
EIF2A Antibody in Immunohistochemistry (Paraffin) (IHC (P))

Search
Proteintech
EIF2A Monoclonal Antibody (1G7H4)
{{$productOrderCtrl.translations['antibody.pdp.commerceCard.promotion.promotions']}}
{{$productOrderCtrl.translations['antibody.pdp.commerceCard.promotion.viewpromo']}}
{{$productOrderCtrl.translations['antibody.pdp.commerceCard.promotion.promocode']}}: {{promo.promoCode}} {{promo.promoTitle}} {{promo.promoDescription}}. {{$productOrderCtrl.translations['antibody.pdp.commerceCard.promotion.learnmore']}}
产品信息
66482-1-IG
种属反应
宿主/亚型
分类
类型
克隆号
抗原
偶联物
形式
浓度
规格
纯化类型
保存液
内含物
保存条件
运输条件
产品详细信息
Immunogen sequence: IASTDVDKT GASYYGEQTL HYIATNGESA VVQLPKNGPI YDVVWNSSST EFCAVYGFMP AKATIFNLKC DPVFDFGTGP RNAAYYSPHG HILVLAGFGN LRGQMEVWDV KNYKLISKPV ASDSTYFAWC PDGEHILTAT CAPRLRVNNG YKIWHYTGSI LHKYDVPSNA ELWQVSWQPF LDGIFPAKTI TYQAVPSEVP NEEPKVATAY RPPALRNKPI TNSKLHEEEP PQNMKPQSGN DKPLSKTALK NQRKHEAKKA AKQEARSDKS PDLAPTPAPQ STPRNTVSQS ISGDPEIDKK IKNLKKKLKA IEQLKEQAAT GKQLEKNQLE KIQKETALLQ ELEDLKLGI (238-585 aa encoded by BC011885)
靶标信息
EIF2A is a 65-kD protein that catalyzes the formation of puromycin-sensitive 80S preinitiation complexes.
仅用于科研。不用于诊断过程。未经明确授权不得转售。
生物信息学
蛋白别名: 65 kDa eukaryotic translation initiation factor 2A; CDA02; EIF-2A; eIF2A; Eukaryotic translation initiation factor 2A; eukaryotic translation initiation factor 2A, 65kDa; MST089; MSTP004; MSTP089; unnamed protein product
基因别名: CDA02; D030048D22; D3Ertd194e; EIF-2A; EIF2A; MST089; MSTP004; MSTP089
UniProt ID: (Human) Q9BY44, (Mouse) Q8BJW6
Entrez Gene ID: (Human) 83939, (Rat) 502531, (Mouse) 229317